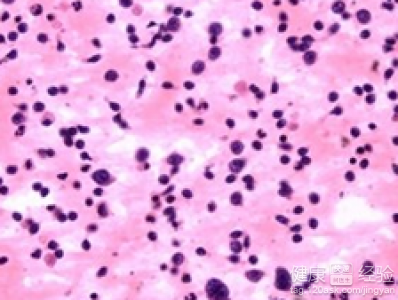
安裝心髒起搏器後還會出現早搏嗎

室性早搏是一個比較糟糕的疾病的,而且病人往往會有心髒停跳的感覺的,而且病人其實有不同程度的高血壓的症狀,甚至有得病人不僅僅有冠心病,甚至也有的病人有心肌病的存在的。而且我們知道的,有風濕性心髒病病史的病人,比較容易有室性早搏的症狀的。室性早搏如果勃起治療的時候,那麼病人的症狀會越來越嚴重起來的了。那麼到底安裝心髒起搏器後還會出現早搏嗎?
1安裝心髒起搏器後還會出現早搏嗎?這個我想是大家非常關心的話題的,有的病人甚至要看看是否會容易有早搏的話,去考慮要不要去做安裝心髒起搏器的手術的,和病人的病情也是有關系的。
2早搏的出現與起搏器本身關系不大的,建議在安裝起搏器以後,還出現早搏的症狀的時候,自己不可以隨隨便便吃藥的,而且也不要破罐子破摔,不去做任何的治療的,需要積極的治療。

3安裝心髒起搏器後還會出現早搏的病人,不要拖拖拉拉的,建議病人需要進一步到大醫院和心髒專科的醫院裡面,去進一步做動態心電圖檢查,需要進一步確定心律失常的類型的。
安裝心髒起搏器後還會出現早搏的病人,不要拖拖拉拉的,建議病人需要進一步到大醫院裡面和心髒專科的醫院裡面,去進一步做動態心電圖檢查,